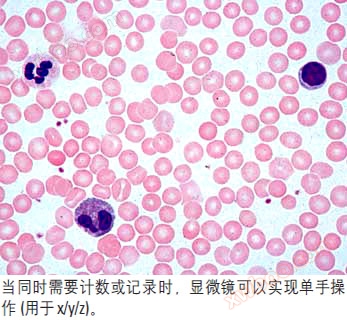

LEICA DM 1000 DM 2000 DM 2500 DM 3000シリーズ顕微鏡は異なる応用を満たすことができる:
◇LEICA DM 1000は、人間化要件の使用と光学的明瞭性の要件をすべて満たし、臨床実験室の応用に最も理想的である。
◇LEICA DM 2000には精密なフォーカス機械装置があり、5つのフォーカス機能があり、2歯車または3歯車のフォーカス調整、トルク調整、および調節ステージを選択して制限位置に教えることができる。
◇LEICA DM 2500は大電力の100 W照明ランプであり、特に微分干渉位相ライニング(DIC)などの観察方法を必要とする場合に適している。
◇LEICA DM 3000のインテリジェント化操作は医療診断の作業効率を大幅に向上させる。臨床およびその他すべての生物医学の一般的な応用と研究のために設計された。
◇この4モデルすべてに蛍光を装備することができます。

DM 1000、DM 2000、DM 2500、DM 3000の共通の主な特徴:
◇高さ調整可能なフォーカスノブ:

◇調整可能な鏡筒leicadMシリーズには、さまざまな観察筒が用意されています。観察時に人間の生産性に合った15°の観察角度を持つ新しい鏡筒またはリラックスするための頭部位置を持つ調整可能なVario鏡筒を選択します。首や背中の筋肉の疲労を防ぎ、肩や下首の筋肉のリラックスに役立ち、超長時間働いても疲れません。


◇フォーカスノブとステージノブは同じ高さで操作者と同じ距離で対称操作を実現する。
◇超硬メサ。新しいセラミック材料で作られ、これまでのどの材料よりも頑丈で耐摩耗性があります。
◇カラーマーカー付き絞り設定は、迅速な識別と調整に便利です。集光レンズ上の有効な絞り目盛には、対物レンズの標準色コードに対応する色標識記号が表示されており、これにより、ユーザーは一目で現在の対物レンズに最もマッチする絞り位置を見つけることができる。

◇平場HI PLAN対物レンズは平場と色差補正の改善に有利である。HI PLAN 10 X対物レンズは細胞学などの臨床応用に適しており、12.1 mmの長動作距離があり、10 X対物レンズの下でマーキングすることができる。
◇同期輝度対物レンズ4 X、10 X、40 Xの倍率を持つ新HI PLAN SL(同歩光)対物レンズシリーズは目を楽しませてくれます。これらの対物レンズは、どの増幅倍率を選択しても輝度が変わらないように、光強度を通して動作することができます。これにより、対物レンズを変更する際に輝度を繰り返し調整する必要がなくなり、色効果が最適に維持されます。
◇HI PLAN CY専門対物レンズ専門のHI LAN CY 10 X/0.25対物レンズは優れた領域整合と色補正を持ち、同時に臨床に12 mmの長作動距離を提供した。同様にSL(同歩光)モデルがある。
◇マクロ対物レンズ1.25 X拡大倍率対物レンズ。
◇「ゼロ画素ドリフト」を持つ新しい蛍光軸は、フィルタブロックを変換する際に画像がシフトしないことを確保し、画像を正確に重畳するのに便利である。5つのフィルタブロック位置が提供され、ユーザーはそれらの間を迅速に変換することができます。
LEICA DM 3000自動顕微鏡特有の機能:
◇インテリジェントで革新的な新型自動顕微鏡LEICA DM 3000。LEICA DM 3000は、独自のtoggleモードと自動集光器により、迅速かつ正確に動作し、すべての生物医学の一般的な応用と研究分野においてより高い安全信頼性を持っています。
◇DM 3000自動顕微鏡電動対物レンズターンテーブルにより、対物レンズの倍率をわずか半秒で変更できます。目を対物レンズから離す必要がなく、両手をその場に保つことができ、タッチボタンによって対物レンズの変換を実現することができる。
◇ターンテーブルはフォーカスノブのすぐ後ろにある2つのボタンで制御されます。6つの対物レンズのうちのいずれか2つを、この2つのボタンによって倍率を繰り返し交換する目的(つまりtoggleモード)に設定することができます。顕微鏡の先端にある6つのボタンは、それぞれ6つの対物レンズを制御する。


◇自動集光ミラートップミラー:LEICA DM 3000の集光ミラートップミラー(補助集光ミラー)は、対物レンズの倍率に応じて自動的にスピンアウトおよびスピンインすることができる。
◇最適光強度の自動調整:LEICA DM 3000は、対物レンズを変換するために光の輝度を調整しなければならない手間を減らすために、異なる対物レンズに基づいて最適光強度を自動的に調整することができる。及び操作者の眼精疲労を減少させる。

DM 1000 DM 2000 DM 3000詳細構成表:
| 推薦サプライヤー:大悦維佳(北京)科技有限公司 | DM1000 | DM2000 | DM2200型 | DM3000 | ||
|---|---|---|---|---|---|---|
| ステント | 電源 | 30 Wで90 ~ 250 Vの間で自動調整できる内蔵電源 | ✔ | ✔ | ✔ | |
| 100 Wで90 ~ 250 Vの間で自動調整できる内蔵電源 | ✔ | |||||
| コエラー | 各種koehler照明装置 | ✔ | ✔ | ✔ | ✔ | |
| 所定式koehler照明 | ✔ | ✔ | ✔ | ✔ | ||
| 鏡筒 | Ergo鏡筒15°観察角度FOV 22° | ✔ | ✔ | ✔ | ✔ | |
| 標準鏡筒、30°観察角度FOV 22 | ✔ | ✔ | ✔ | ✔ | ||
| Ergo傾斜鏡筒FOV 25(長) | ✔ | ✔ | ✔ | ✔ | ||
| Ergo傾斜鏡筒FOV 22(短) | ✔ | ✔ | ✔ | ✔ | ||
| 高級Ergo傾斜鏡筒FOV 22 | ✔ | ✔ | ✔ | ✔ | ||
| カメラシリンダ | 三眼Ergo傾斜鏡筒50/50 22 FOV 22 | ✔ | ✔ | ✔ | ✔ | |
| 三眼Ergo傾斜鏡筒100/100 25 FOV 22 | ✔ | ✔ | ✔ | ✔ | ||
| 三眼Ergo傾斜鏡筒50/50 FOV 25 | ✔ | ✔ | ✔ | ✔ | ||
| BDT 25 0/50/100デュアルポートオプションFOV 25 | ✔ | ✔ | ✔ | ✔ | ||
| 三目50/50 FOV 22 | ✔ | ✔ | ✔ | ✔ | ||
| Ergoモジュール | 30mm | ✔ | ✔ | ✔ | ✔ | |
| 60ミリメートル | ✔ | ✔ | ✔ | ✔ | ||
| 操作 | フォーカス | 高さ調整式フォーカスノブ | ✔ | ✔ | ✔ | ✔ |
| 2速焦点調整:粗調整、微調整、焦点制限 | ✔ | |||||
| 5速フォーカス機能:2ギアまたは3ギアフォーカス、フォーカスリミット、調整可能トルク | ✔ | ✔ | ✔ | |||
| 対物レンズ変換盤 | 5ビット | ✔ | ||||
| 6ビット | ✔ | ✔ | ||||
| 7ビット | ✔ | ✔ | ||||
| 追加のtoggleモード付き自動6ビット対物レンズターンテーブル | ✔ | |||||
| 対物レンズ | 輝度同期対物レンズシリーズ4 X、10 X、40 X | ✔ | ✔ | ✔ | ✔ | |
| 光強度調整 | 異なる増幅倍率に対応する自動光強度調整 | ✔ | ||||
| ステージ | 超硬セラミックテーブル | ✔ | ✔ | ✔ | ✔ | |
| 左手または右手で操作(ユーザーは自分で変更できます) | ✔ | ✔ | ✔ | ✔ | ||
| ばくはつぼう | ✔ | ✔ | ✔ | ✔ | ||
| 伸縮式X−Y駆動装置 | ✔ | ✔ | ✔ | ✔ | ||
| トルク調整可能 | ✔ | ✔ | ✔ | ✔ | ||
| 回転可能/2つのスライドのためのステージ | ✔ | ✔ | ✔ | ✔ | ||
| TL軸 | 照明 | 12 V/30 Wハロゲンランプ、交換が非常に便利 | ✔ | ✔ | ✔ | |
| 12 V/100 Wハロゲン電球、ランプボックス付き | ✔ | |||||
| 専門サプライヤー:大悦維佳(北京)科技有限公司 | ✔ | ✔ | ✔ | ✔ | ||
| フィルタエレメント | ねじ込み式青色フィルタ | ✔ | ✔ | ✔ | ✔ | |
| 2つのフィルター用フィルターフレーム | ✔ | ✔ | ✔ | |||
| 3つのフィルター用フィルターフレーム | ✔ | ✔ | ✔ | |||
| 3つのフィルター用の内蔵フィルター | ✔ | |||||
| 集光レンズ | 標準集光レンズCL/PH、カラーマーキング(2.5 X-100 X) | ✔ | ✔ | ✔ | ✔ | |
| Achr.Apl反転カバー集光鏡、上色標識(1.25 X-100 X) | ✔ | |||||
| 自動Achr.Apl反転カバー集光鏡、上色標識(1.25 X-100 X) | ✔ | |||||
| 汎用集光レンズUCL BF/位相/DF | ✔ | ✔ | ✔ | ✔ | ||
| 汎用集光レンズUCA BF/位相/DF/DIC | ✔ | ✔ | ✔ | |||
| たいひほう | BF | ✔ | ✔ | ✔ | ✔ | |
| DF、PH、POL | ✔ | ✔ | ✔ | ✔ | ||
| DIC | ✔ | ✔ | ✔ | |||
| けいこうじく | しょうめいそうち | 50 W水銀ランプ | ✔ | ✔ | ✔ | ✔ |
| 75 W水銀ランプ | ✔ | ✔ | ✔ | ✔ | ||
| 100 W水銀ランプ | ✔ | ✔ | ✔ | ✔ | ||
| 12 V/100 Wハロゲンランプ | ✔ | ✔ | ✔ | ✔ | ||
| 蛍光フィルタコンバータ | 3ビットスライダ、蛍光フィルタ用 | ✔ | ||||
| 5ビット蛍光フィルタブロックターンテーブル | ✔ | ✔ | ✔ | |||

